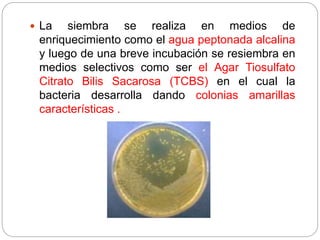
 La siembra se realiza en medios de
enriquecimiento como el agua peptonada alcalina
y luego de una breve incubación se resiembra en
medios selectivos como ser el Agar Tiosulfato
Citrato Bilis Sacarosa (TCBS) en el cual la
bacteria desarrolla dando colonias amarillas
características .
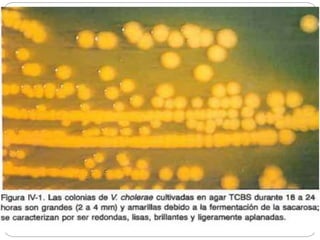
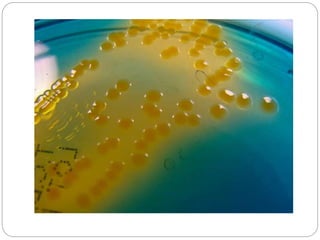
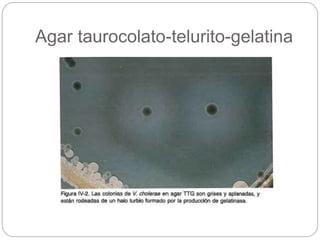
Agar taurocolato-telurito-gelatina
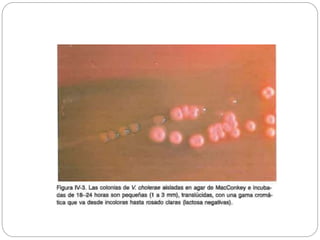

Vibrio cholerae es la bacteria causante del cólera. Es un bacilo Gram negativo móvil con un flagelo polar que se clasifica en serotipos, siendo O1 y O139 los productores de cólera. El cólera causa una diarrea acuosa severa y deshidratación grave si no se trata, propagándose por el agua y los alimentos contaminados. El diagnóstico se confirma por cultivo bacteriológico e identificación serológica, y el tratamiento consiste en rehidratación oral o intravenosa y